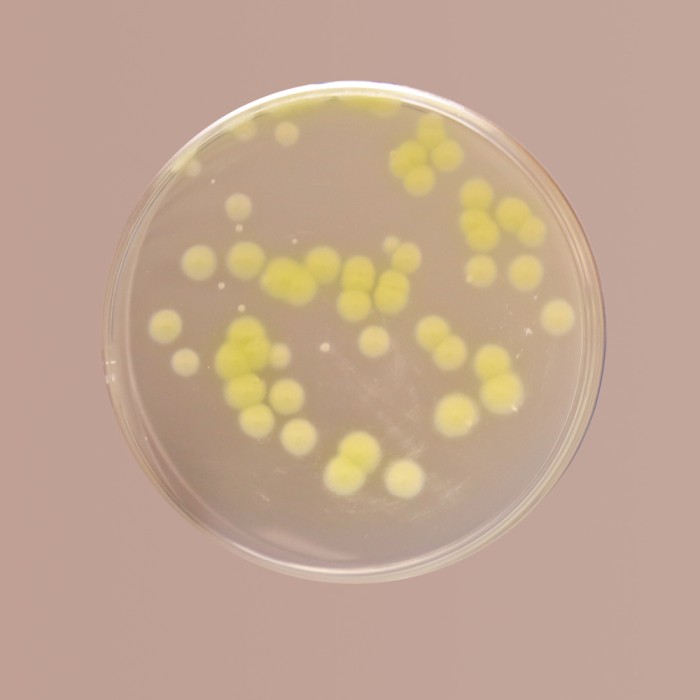
Cetrimide Agar, Granulated

Your enquiry has been submitted
Drake’s Medium 10
Intended use
Recommended for for cultivation of Pseudomonas species from water samples.
Composition
| Ingredients | Gms / Litre |
|---|---|
| DL-Asparagine | 3.20 |
| L-Proline | 1.60 |
| Dipotassium hydrogen phosphate | 1.60 |
| Magnesium sulphate | 0.80 |
| Potassium sulphate | 16.000 |
Directions
Suspend 23.2 grams in 1000 ml purified / distilled water containing 38.6 ml ethanol. Heat to boiling to dissolve the medium completely. Dispense in tubes or flasks or as deisred. Sterilize by autoclaving at 15 lbs pressure (121°C) for 15 minutes.
Principle And Interpretation
This medium is used for cultivation of Pseudomonas species from water samples. It is relatively simple medium containing amino acids, DL-Asparagine and L-Proline, these two serve as nitrogen sources while magnesium salts provide the ions for the growth of Pseudomonas species. Dipotassium hydrogen phosphate helps in maintaining buffering conditions of the medium.
Type of specimen
Water samples
Specimen Collection and Handling
For water samples, follow appropriate techniques for sample collection, processing as per guidelines and local standards(1). After use, contaminated materials must be sterilized by autoclaving before discarding.
Warning and Precautions
Read the label before opening the container. Wear protective gloves/protective clothing/eye protection/ face protection. Follow good microbiological lab practices while handling specimens and culture. Standard precautions as per established guidelines should be followed while handling specimens. Safety guidelines may be referred in individual safety data sheets.
Limitations
- Individual organisms differ in their growth requirement and may show variable growth patterns on the medium.
- Each lot of the medium has been tested for the organisms specified on the COA. It is recommended to users to validate the medium for any specific microorganism other than mentioned in the COA based on the user's unique requirement.
Performance and Evaluation
Performance of the medium is expected when used as per the direction on the label within the expiry period when stored at recommended temperature.
Quality Control
Appearance: White coloured, homogeneous, free flowing powder.
Colour and Clarity of prepared medium: Clear colourless solution, having some white precipitate.
Cultural Response: Cultural characteristics observed after an incubation at 35-37°C for 18-24 hours
| Organism | Inoculum (CFU) | Growth |
|---|---|---|
| Pseudomonas aeruginosa ATCC 27853 (00025*) | 50-100 | luxuriant |
| Stenotrophomonas maltophilia ATCC 13637 | 50-100 | luxuriant |
Key: *Corresponding WDCM numbers.
Storage and Shelf Life
Store between 10-30°C in a tightly closed container and the prepared medium at 15-25°C. Use before expiry date on the label. On opening, product should be properly stored dry, after tightly capping the bottle in order to prevent lump formation due to the hygroscopic nature of the product. Improper storage of the product may lead to lump formation. Store in dry ventilated area protected from extremes of temperature and sources of ignition. Seal the container tightly after use. Product performance is best if used within stated expiry period.
Disposal
User must ensure safe disposal by autoclaving and/or incineration of used or unusable preparations of this product. Follow established laboratory procedures in disposing of infectious materials and material that comes into contact with sample must be decontaminated and disposed of in accordance with current laboratory techniques (2,3).
Reference
- Baird R.B., Eaton A.D., and Rice E.W., (Eds.), 2015, Standard Methods for the Examination of Water and Wastewater, 23rd ed., APHA, Washington, D.C.
- Isenberg, H.D. Clinical Microbiology Procedures Handbook 2nd Edition.
- Jorgensen, J.H., Pfaller, M.A., Carroll, K.C., Funke, G., Landry, M.L., Richter, S.S and Warnock., D.W. (2015) Manual of Clinical Microbiology, 11th Edition. Vol. 1.
| Product Name | Drake’s Medium 10 |
|---|---|
| SKU | M1261 |
| Product Type | Regular |
| Physical Form | Powder |
| Origin | Chemically defined |
| Packaging type | HDPE |
| References | 1. Baird R.B., Eaton A.D., and Rice E.W., (Eds.), 2015, Standard Methods for the Examination of Water and Wastewater, 23rd ed., APHA, Washington, D.C. 2. Isenberg, H.D. Clinical Microbiology Procedures Handbook 2nd Edition. 3. Jorgensen, J.H., Pfaller, M.A., Carroll, K.C., Funke, G., Landry, M.L., Richter, S.S and Warnock., D.W. (2015) Manual of Clinical Microbiology, 11th Edition. Vol. 1. |